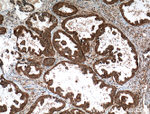
APOBEC3C Antibody in Immunohistochemistry (Paraffin) (IHC (P))
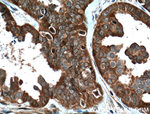
APOBEC3C Antibody in Immunohistochemistry (Paraffin) (IHC (P))
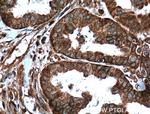
APOBEC3C Antibody in Immunohistochemistry (Paraffin) (IHC (P))
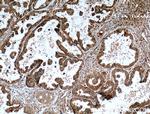
APOBEC3C Antibody in Immunohistochemistry (Paraffin) (IHC (P))

Search
Proteintech
APOBEC3C Polyclonal Antibody
{{$productOrderCtrl.translations['antibody.pdp.commerceCard.promotion.promotions']}}
{{$productOrderCtrl.translations['antibody.pdp.commerceCard.promotion.viewpromo']}}
{{$productOrderCtrl.translations['antibody.pdp.commerceCard.promotion.promocode']}}: {{promo.promoCode}} {{promo.promoTitle}} {{promo.promoDescription}}. {{$productOrderCtrl.translations['antibody.pdp.commerceCard.promotion.learnmore']}}
产品信息
10591-1-AP
种属反应
已发表种属
宿主/亚型
分类
类型
抗原
偶联物
形式
浓度
规格
纯化类型
保存液
内含物
保存条件
运输条件
产品详细信息
Immunogen sequence: MNPQIRNPM KAMYPGTFYF QFKNLWEAND RDETWLCFTV EGIKRRSVVS WKTGVFRNQV DSETHCHAER CFLSWFCDDI LSPNTKYQVT WYTSWSPCPD CAGEVAEFLA RHSNVNLTIF TARLYYFQYP CYQEGLRSLS QEGVAVEIMD YEDFKYCWEN FVYNDNEPFK PWKGLKTNFR LLKRRLRESL Q (1-190 aa encoded by BC011739)
靶标信息
APOBEC (apolipoprotein B mRNA editing enzyme, catalytic) proteins inhibit retroviruses by deaminating cytosine residues of viral RNA and DNA. The seven APOBEC3 genes or pseudogenes are found in a cluster thought to result from gene duplication on chromosome 22. Like APOBEC3G, APOBEC3F deaminates deoxycytosine to deoxyuracil in the minus strand of HIV-1 DNA, resulting in G to A hypermutation in the plus strand of DNA. Thus, APOBEC3G and APOBEC3F provide a mechanism for innate immunity to retroviruses, and are also likely contribute to sequence variation observed in many viruses. Viral infectivity factor (Vif) imparts APOBEC3G and APOBEC3F resistance to HIV through impaired translation of their mRNA and accelerated posttranslational degradation of the APOBEC3 proteins by the 26S proteasome. Interestingly, HIV-1 Vif cannot form a complex with APOBEC3G or APOBEC3F of mouse origin as it does with the human protein, and thus mouse APOBEC3G and APOBEC3F function as a potent inhibitors of wildtype HIV-1 replication, where human APOBEC3G and APOBEC3F are only able to inhibit Vif-deficient HIV-1 replication. This implies that induction of APOBEC3G and APOBEC3F activity or a method of blocking their interaction with Vif may provide a method for therapeutic intervention.
仅用于科研。不用于诊断过程。未经明确授权不得转售。
生物信息学
蛋白别名: A3C; APOBEC1-like; apolipoprotein B editing enzyme catalytic polypeptide-like 3C; apolipoprotein B mRNA editing enzyme, catalytic polypeptide-like 3C; bK150C2.3; DNA dC->dU-editing enzyme APOBEC-3C; MGC19485; Phorbolin I; probable DNA dC->dU-editing enzyme APOBEC-3C; unnamed protein product
基因别名: A3C; APOBEC1L; APOBEC3C; ARDC2; ARDC4; ARP5; bK150C2.3; PBI
UniProt ID: (Human) Q9NRW3
Entrez Gene ID: (Human) 27350